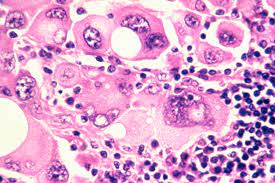

Buffalo, Jan 18: Media outlets have reported the encouraging findings of clinical trials for a new experimental vaccine developed by the biotech company Moderna to treat an aggressive type of skin cancer called melanoma.
Although this is potentially very good news, it occurred to me that the headlines may be unintentionally misleading.
The vaccines most people are familiar with prevent disease, whereas this experimental new skin cancer vaccine treats only patients who are already sick. Why is it called a vaccine if it does not prevent cancer?
I am a biochemist and molecular biologist studying the roles that microbes play in health and disease. I also teach cancer genetics to medical students and am interested in how the public understands science.
While preventive and therapeutic vaccines are administered for different health care goals, they both train the immune system to recognise and fight off a specific disease agent that causes illness.
How do preventive vaccines work?
Most vaccines are administered to healthy people before they get sick to prevent illnesses caused by viruses or bacteria. These include vaccines that prevent polio, measles, COVID-19 and many other diseases.
Researchers have also developed vaccines to prevent some types of cancers that are caused by such viruses as the human papillomaviruses and Epstein-Barr virus.
Your immune system recognises objects such as certain microbes and allergens that do not belong in your body and initiates a series of cellular events to attack and destroy them.
Thus, a virus or bacterium that enters the body is recognised as something foreign and triggers an immune response to fight off the microbial invader. This results in a cellular memory that will elicit an even faster immune response the next time the same microbe intrudes.
The problem is that sometimes the initial infection causes serious illness before the immune system can mount a response against it. While you may be better protected against a second infection, you have suffered the potentially damaging consequences of the first one.
This is where preventive vaccines come in. By introducing a harmless version or a portion of the microbe to the immune system, the body can learn to mount an effective response against it without causing the disease.
For example, the Gardasil-9 vaccine protects against the human papillomavirus, or HPV, which causes cervical cancer. It contains protein components found in the virus that cannot cause disease but do elicit an immune response that protects against future HPV infection, thereby preventing cervical cancer.
How does the Moderna cancer vaccine work?
Unlike cervical cancer, skin melanoma isn’t caused by a viral infection, according the latest evidence. Nor does Moderna’s experimental vaccine prevent cancer as Gardasil-9 does.
The Moderna vaccine trains the immune system to fight off an invader in the same way preventive vaccines most people are familiar with do. However, in this case the invader is a tumour, a rogue version of normal cells that harbours abnormal proteins that the immune system can recognise as foreign and attack.
What are these abnormal proteins and where do they come from?
All cells are made up of proteins and other biological molecules such as carbohydrates, lipids and nucleic acids. Cancer is caused by mutations in regions of genetic material, or DNA, that encode instructions on what proteins to make.
Mutated genes result in abnormal proteins called neoantigens that the body recognises as foreign. That can trigger an immune response to fight off a nascent tumor. However, sometimes the immune response fails to subdue the cancer cells, either because the immune system is unable to mount a strong enough response or the cancer cells have found a way to circumvent the immune system’s defences.
Moderna’s experimental melanoma vaccine contains genetic information that encodes for portions of the neoantigens in the tumour. This genetic information is in the form of mRNA, which is the same form used in the Moderna and Pfizer-BioNtech COVID-19 vaccines. Importantly, the vaccine cannot cause cancer, because it encodes for only small, nonfunctional parts of the protein.
When the genetic information is translated into those protein pieces in the body, they trigger the immune system to mount an attack against the tumour. Ideally, this immune response will cause the tumour to shrink and disappear.
Notably, the Moderna melanoma vaccine is tailor-made for each patient. Each tumour is unique, and so the vaccine needs to be unique as well. To customise vaccines, researchers first biopsy the patient’s tumour to determine what neoantigens are present.
The vaccine manufacturer then designs specific mRNA molecules that encode those neoantigens. When this custom mRNA vaccine is administered, the body translates the genetic material into proteins specific to the patient’s tumour, resulting in an immune response against the tumour.
Combining vaccination with immunotherapy
Vaccines are a form of immunotherapy, because they treat diseases by harnessing the immune system. However, other immunotherapy cancer drugs are not vaccines because, while they also stimulate the immune system, they do not target specific neoantigens.
In fact, the Moderna vaccine is co-administered with the immunotherapy drug pembrolizumab, which is marketed as Keytruda. Why are two drugs needed?
Certain immune cells called T-cells have molecular accelerator and brake components that serve as checkpoints to ensure they are revved up only in the presence of a foreign invader such as a tumour. However, sometimes tumour cells find a way to keep the T-cell brakes on and suppress the immune response. In these cases, the Moderna vaccine correctly identifies the tumour, but T-cells cannot respond to it.
Pembrolizumab, however, can bind directly to a brake component on the T-cell, inactivating the brake system and allowing the immune cells to attack the tumour.
Not a preventive cancer vaccine
So why can’t the Moderna vaccine be administered to healthy people to prevent melanoma before it arises?
Cancers are highly variable from person to person. Each melanoma harbours a different neoantigen profile that cannot be predicted in advance. Therefore, a vaccine cannot be developed in advance of the illness.
The experimental mRNA melanoma vaccine, currently still in early-phase clinical trials, is an example of the new frontier of personalised medicine. By understanding the molecular basis of diseases, researchers can explore how their underlying causes vary among people, and offer personalised therapeutic options against those diseases. (The Conversation)
(AGENCIES)